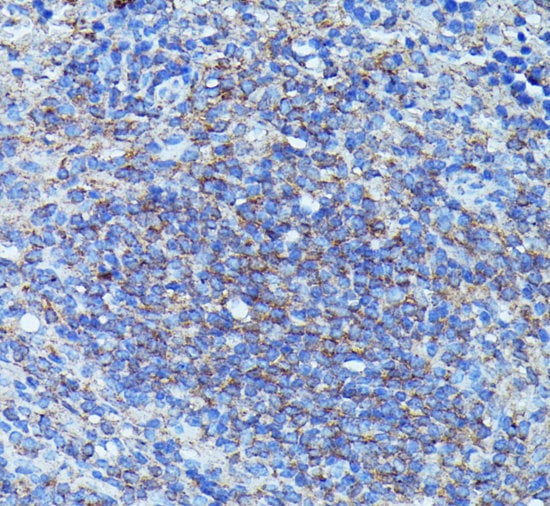
product-image-AAA177660_IHC11.jpg

Human Granulocyte Colony-Stimulating Factor, CSF3 ELISA Kit | CSF3 elisa kit
Human Granulocyte Colony-Stimulating Factor, CSF3 Primacu ELISA Kit
Gene Names
CSF3; GCSF; CSF3OS; C17orf33
Reactivity
Human
Synonyms
Granulocyte Colony-Stimulating Factor, CSF3; N/A; Human Granulocyte Colony-Stimulating Factor, CSF3 Primacu ELISA Kit; Granulocyte colony-stimulating factor; G-CSF; C17orf33; GCSF; CSF3 elisa kit
Reactivity
Human
Assay Type
Sandwich
Samples
Serum, plasma, cell culture supernates
Detection Range
93.75-6000pg/mL
Sensitivity
16.98pg/mL
Standard Solution
60ng/mL
Assay Time
3.5h
Preparation and Storage
Store at 2-8 degree C
Related Product Information for CSF3 elisa kit
Granulocyte-colony stimulating factor (G-CSF) is a growth factor and an essential cytokine belonging to the CSF family of hormone-like glycoproteins. It is produced by numerous cell types including immune and endothelial cells. G-CSF binding to its receptor G-CSF-R which belongs to the cytokine receptor type I family depends on the interaction of alpha-helical motifs of the former and two fibronectin type III as well as an immunoglobulin-like domain of the latter. Recent animal studies have also revealed that G-CSF activates multiple signaling pathways, such as Akt and also the Janus family kinase-2 and signal transducer and activation of transcription-3 (Jak2-STAT3) pathway, thereby promoting survival, proliferation, differentiation and mobilisation of haematopoietic stem and progenitor cells. G-CSF is a cytokine that have been demonstrated to improve cardiac function and perfusion in myocardial infarction. And it was initially evaluated as a stem cell mobilizer and erythropoietin as a cytoprotective agent. G-CSF prevents left ventricular remodeling after myocardial infarction by decreasing cardiomyocyte death and by increasing the number of blood vessels, suggesting the importance of direct actions of G-CSF on the myocardium rather than through mobilization and differentiation of stem cells. Accordingly, recombinant human (rh)G-CSF has been extensively used in clinical haematology and oncology to enable bone marrow transplantation or to treat chemotherapy-associated neutropenia. In preclinical study, G-CSF improved cardiac function and perfusion by angiomyogenesis and protection of cardiomyocytes in myocardial infarction. Cancer Immunotherapy Immune Checkpoint Immunotherapy Targeted Therapy
Product Categories/Family for CSF3 elisa kit
NCBI and Uniprot Product Information
NCBI GI #
NCBI GeneID
NCBI Accession #
NCBI GenBank Nucleotide #
Molecular Weight
22,293 Da
NCBI Official Full Name
granulocyte colony-stimulating factor isoform d
NCBI Official Synonym Full Names
colony stimulating factor 3 (granulocyte)
NCBI Official Symbol
CSF3
NCBI Official Synonym Symbols
GCSF; CSF3OS; C17orf33
NCBI Protein Information
granulocyte colony-stimulating factor; filgrastim; lenograstim; pluripoietin
UniProt Protein Name
Granulocyte colony-stimulating factor
UniProt Gene Name
CSF3
UniProt Synonym Gene Names
C17orf33; GCSF; G-CSF
UniProt Entry Name
CSF3_HUMAN
Customer Reviews
Loading reviews...
Share Your Experience
Similar Products
Product Notes
The Human CSF3 csf3 (Catalog #AAA124130) is an ELISA Kit and is intended for research purposes only. The product is available for immediate purchase. The AAA124130 ELISA Kit recognizes Human CSF3. It is sometimes possible for the material contained within the vial of "Granulocyte Colony-Stimulating Factor, CSF3, ELISA Kit" to become dispersed throughout the inside of the vial, particularly around the seal of said vial, during shipment and storage. We always suggest centrifuging these vials to consolidate all of the liquid away from the lid and to the bottom of the vial prior to opening. Please be advised that certain products may require dry ice for shipping and that, if this is the case, an additional dry ice fee may also be required.Precautions
All products in the AAA Biotech catalog are strictly for research-use only, and are absolutely not suitable for use in any sort of medical, therapeutic, prophylactic, in-vivo, or diagnostic capacity. By purchasing a product from AAA Biotech, you are explicitly certifying that said products will be properly tested and used in line with industry standard. AAA Biotech and its authorized distribution partners reserve the right to refuse to fulfill any order if we have any indication that a purchaser may be intending to use a product outside of our accepted criteria.Disclaimer
Though we do strive to guarantee the information represented in this datasheet, AAA Biotech cannot be held responsible for any oversights or imprecisions. AAA Biotech reserves the right to adjust any aspect of this datasheet at any time and without notice. It is the responsibility of the customer to inform AAA Biotech of any product performance issues observed or experienced within 30 days of receipt of said product. To see additional details on this or any of our other policies, please see our Terms & Conditions page.Item has been added to Shopping Cart
If you are ready to order, navigate to Shopping Cart and get ready to checkout.